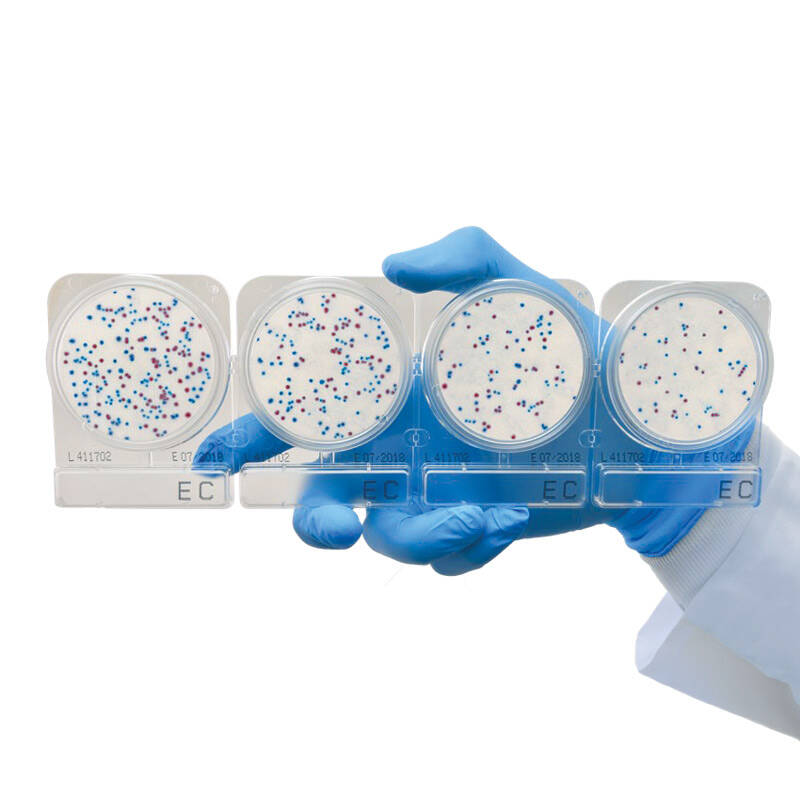
Готовые хромогенные среды

-
Зерновые культуры
- Процессы, необходимые для исследования зерновых культур
-
Показатели качества зерна
- Сорность, зараженность вредителями
- Натура
- Стекловидность
-
Влажность
- Сушильные шкафы для зерна
- Анализаторы влажности зерна
- Влагомеры зерна
-
ИК-анализаторы для контроля уровня влажности в зерне
- Инфракрасные анализаторы цельного зерна AgriCheck для контроля уровня влажности
- ИК-анализатор зерна, кормов и пищевых продуктов SpectraStar XT Unity Scientific
- Портативный ИК-анализатор цельного зерна IAS 3120, Intelligent Analysis Service для контроля уровня влажности
- ИК анализатор QuikCheck
- Потоковые анализаторы зерна для производственных линий
- Портативный ИК-анализатор SCIO Cup
-
Белок
-
ИК-анализаторы
- Портативный ИК-анализатор цельного зерна IAS 3120, Intelligent Analysis Service для контроля уровня белка
- Инфракрасные анализаторы цельного зерна AgriCheck для контроля уровня белка
- Потоковые анализаторы для производственных линий
- ИК-анализатор зерна, кормов и пищевых продуктов SpectraStar XT Unity Scientific
- Портативный ИК-анализатор SCIO Cup
- Определение белка в зерне методом Кьельдаля
- Определение белка методом Дюма
-
ИК-анализаторы
- Маслянистость
- Клетчатка
- Зольность
-
Клейковина
- Система для определения количества и качества клейковины в зерне механическим методом
- Набор для определения количества и качества клейковины ручным методом
-
ИК-анализаторы
- Портативный ИК-анализатор цельного зерна IAS 3120, Intelligent Analysis Service для контроля качества клейковины
- Инфракрасные анализаторы цельного зерна AgriCheck для контроля уровня клейковины
- ИК-анализатор зерна, кормов и пищевых продуктов SpectraStar XT Unity Scientific
- Портативный ИК-анализатор SCIO Cup
- Число падения
- Микотоксины
- ГМО в зерне
- Сажка
- Радионуклиды
- Токсичные элементы
- Пестициды
-
Масличные культуры
- Процессы
-
Показатели качества масличных культур
- Сорная и масличная примесь, зараженность
- Натура
-
Влажность
- Сушильные шкафы
- Анализаторы влажности
- Влагомеры зерна
-
ИК-анализаторы
- Инфракрасные анализаторы цельного зерна AgriCheck для контроля уровня влажности в масличных культурах
- Портативный ИК-анализатор цельного зерна IAS 3120, Intelligent Analysis Service для контроля уровня влажности в масличных культурах
- ИК анализатор QuikCheck
- Потоковые анализаторы для производственных линий
- ИК-анализатор зерна, кормов и пищевых продуктов SpectraStar XT Unity Scientific
- Портативный ИК-анализатор SCIO Cup
-
Белок
-
ИК-анализаторы
- Портативный ИК-анализатор SCIO Cup
- Инфракрасные анализаторы цельного зерна AgriCheck
- Портативный ИК-анализатор цельного зерна IAS 3120, Intelligent Analysis Service для контроля уровня белка в масличных культурах
- Потоковые анализаторы для производственных линий
- ИК-анализатор зерна, кормов и пищевых продуктов SpectraStar XT Unity Scientific
- Определение белка методом Кьельдаля
- Определение белка методом Дюма
-
ИК-анализаторы
-
Жир (масличность)
- Определение жира методом импульсной ЯМР-спектроскопии
- Определение жира методом экстракции
-
ИК-анализаторы
- Портативный ИК-анализатор SCIO Cup
- Инфракрасные анализаторы цельного зерна AgriCheck для контроля уровня жира в масличных культурах
- Портативный ИК-анализатор цельного зерна IAS 3120, Intelligent Analysis Service для контроля уровня жира в масличных культурах
- ИК-анализатор зерна, кормов и пищевых продуктов SpectraStar XT Unity Scientific
- Кислотное число (кислотность)
- Олеиновая кислота
- ГМО
- Микотоксины
- Радионуклиды
- Токсичные элементы
- Пестициды
- Глюкозинолаты
-
Комбикорм
- Процессы
-
Показатели качества комбикормов
- Влажность
- Белок
- Жир (масличность)
- Клетчатка
- Крахмал
- Зольность
- Фосфор
- Кислотность, кальций и содержание соли (NaCl)
- Активность уреазы
- Общая токсичность кормов
- Хрупкость гранул
- Прочность гранул
- Радионуклиды
- Пестициды
- Аминокислотный анализ комбикормов
- Микотоксины
- Витамины
- Тяжелые металлы
-
Масла и жиры
- Процессы, необходимые для исследования масел и жиров
-
Показатели качества растительного масла
- Жир (шрот, жмых)
- Белок (шрот, жмых)
- Клетчатка (шрот, жмых)
- Кислотное число
- Перекисное число
- Анизидиновое число
- Олеиновая кислота
- Фосфорсодержащие вещества (фосфолипиды)
- Цветность
- Йодное число
- Влажность
- Вязкость масла
- Температура вспышки
- Жирнокислотный состав
- Окислительная стабильность
- Контроль гигиены поверхностей и жидкостей
-
Семена
- Процессы
- Показатели качества семян
-
Почва
-
Процессы, необходимые для исследования почвы
- Пробоотбор
- Взвешивание
- Сушка
- Измельчение
- Выделение фракции
- Подготовка воды
- Приготовление вытяжки
- Мойка и дезинфекция
-
Показатели качества почвы
- Кислотность вытяжки почвы
- Общее солесодержание и электропроводность
- Активность ионов
- Азот (нитратная и аммонийная формы)
- Фосфор
- Азот щелочногидролизуемый (по Корнфилду)
- Азот
- Калий
- Кальций и магний (обменные)
- Гранулометрический состав
- Углерод
- Органическое вещество (гумус) в почве
- Микроскопическое исследование почвы
- Элементный состав и загрязнение металлами
- Стойкие органические загрязнители
- Радионуклиды
- Нефтепродукты
- Экспресс-анализ почвы в поле
-
Процессы, необходимые для исследования почвы
-
Молоко
- Процессы, необходимые для исследования молока
-
Показатели качества молока
- Массовая доля сухих веществ в молоке
- Плотность молока
- Кислотность молока
- Чистота молока
- Точка замерзания молока
- Массовая доля жира в молоке
- Массовая доля белка в молоке
- Содержание лактозы
- Микробиологические показатели
- Количество соматических клеток
- Наличие веществ, продлевающих сроки хранения молока
- Остатки антибиотиков
- Содержание мочевины
- Содержание афлатоксина М1
- Токсичные элементы (тяжелые металлы)
- Содержание пестицидов
- Фальсификаты
- Определение эффективности пастеризации
- Определение уровня термообработки
- Термоустойчивость молока
-
Молочные продукты
- Процессы, необходимые для исследования молочных продуктов
-
Показатели качества молочных продуктов
- Аллергены
- Жир
- Белок
- Чистота
- Насыпная плотность
- Размеры кристаллов сахара
- Зола
- Вязкость
- Кухонная соль
- Кислотность
- Свободные жирные кислоты
- Влага и сухие вещества
- Перекисное число жира
- Лактоза
- Плотность
- Сахар
- Бензойная и сорбиновая кислоты
- Натамицин (Е325)
- Жирно-кислотный состав
- Щелочная фосфатаза
- Стериновая фракция и триглицериды
-
Мука
- Процессы, необходимые для исследования муки
-
Показатели качества муки
- Зараженность вредителями, загрязненность и металлопримеси
- Крупность
- Влажность
- Белок
- Клейковина
- Белизна (цвет муки)
- Зольность
- Число падения
- Кислотность
- Микотоксины
- Радионуклиды
- Токсичные элементы
- Пестициды
- Мед
- Мясо и мясные продукты
- Микробиология
-
Безалкогольные напитки
-
Основные показатели качества
- Титрованная и общая кислотность
- рН (активная кислотность)
- Сухие вещества
- Свойства напитков
- Сахара и подсластители
- Гидроксиметилфурфурол
- Витамины
- Микотоксины
- Органические вещества в напитках
- Комплексные показатели питьевой и минеральной воды
- Определение герметичности закупоривания
- Экспресс-анализ на производстве
- Устойчивость
- Мутность
- Пектиновые вещества
- Спирт
- Концентрация СО2
- Цвет
-
Основные показатели качества

Готовые хромогенные среды
- Главная
- Оборудование для исследования
- Микробиология
- Основные процессы
- Подготовка сред
- Питательные среды
-
Готовые хромогенные среды
Это пластины или стерильные чашки Петри, на которые нанесена специфичная среда для каждого типа микроорганизмов. Они предназначены для выявления микроорганизмов в пищевых продуктах, окружающей среде и сырье. Подходят для анализа пищевых продуктов, напитков, косметических средств и других матриц.
Стерильная среда в сухом виде, нанесенная на тканевую подложку. Суспензия исследуемого образца в объеме 1 мл наносится на чашку и диффузионно распределяется на ее поверхности. Результаты определяют после культивирования по количеству выросших на поверхности среды контрастных колоний. Для удобства подсчета на дно чашки или пластины нанесена сетка. Для получения результатов микробиологического тестирования смывов используют удобные свабы с буферным раствором.
Применение готовых стерильных сред позволяет снизить затраты на микробиологические исследования в лаборатории. Это происходит за счет сокращения рабочего времени сотрудников по приготовлению питательных сред и экономии энергоносителей для их стерилизации.
| Маркировка | Применение | Продолжительность инкубации | Температурный режим |
| ТC | Среда для подсчета общего количества микроорганизмов | 48 ч | 35 ± 2 °С |
| ETС | Среда для идентификации Enterococcus | 20–24 ч | 35 ± 2 °С |
| CF | Среда для идентификации колиформ | 18–24 ч |
35 ± 2 °С; 40–42 °С |
| ЕC | Среда для идентификации E. coli й Coliform bacteria (колиформных бактерий) | 24 ч | 35 ± 2 °С |
| YM | Среда для идентификации дрожжей и плесени | 3–7 суток | 25…30 °С |
| YMR | Среда для ускоренной детекции дрожжей и плесневых грибов | 48–72 ч | 25…30 °С |
| PA | Среда для идентификации Pseudomonas aeruginosa | 48 ± 3 ч | 35 ± 1 °С |
| VP | Среда для идентификации Vibrio parahaemolyticus | 18–24 ч | 35–37 °С |
| X-SA | Среда для идентификации Staphylococcus aureus | 24 ч | 35–37 °С |
| X-BC | Среда для идентификации Bacillus cereus | 24 ч | 30 °С |
| SL | Среда для идентификации Salmonella | 20–24 ч | 41…43 °С |
| LS | Среда для идентификации Listeria spp. | 24 ч | 35…37 °С |
| LM | Среда для идентификации Listeria monocytogenes | 24 ± 2 ч | 37 ± 1 °С |